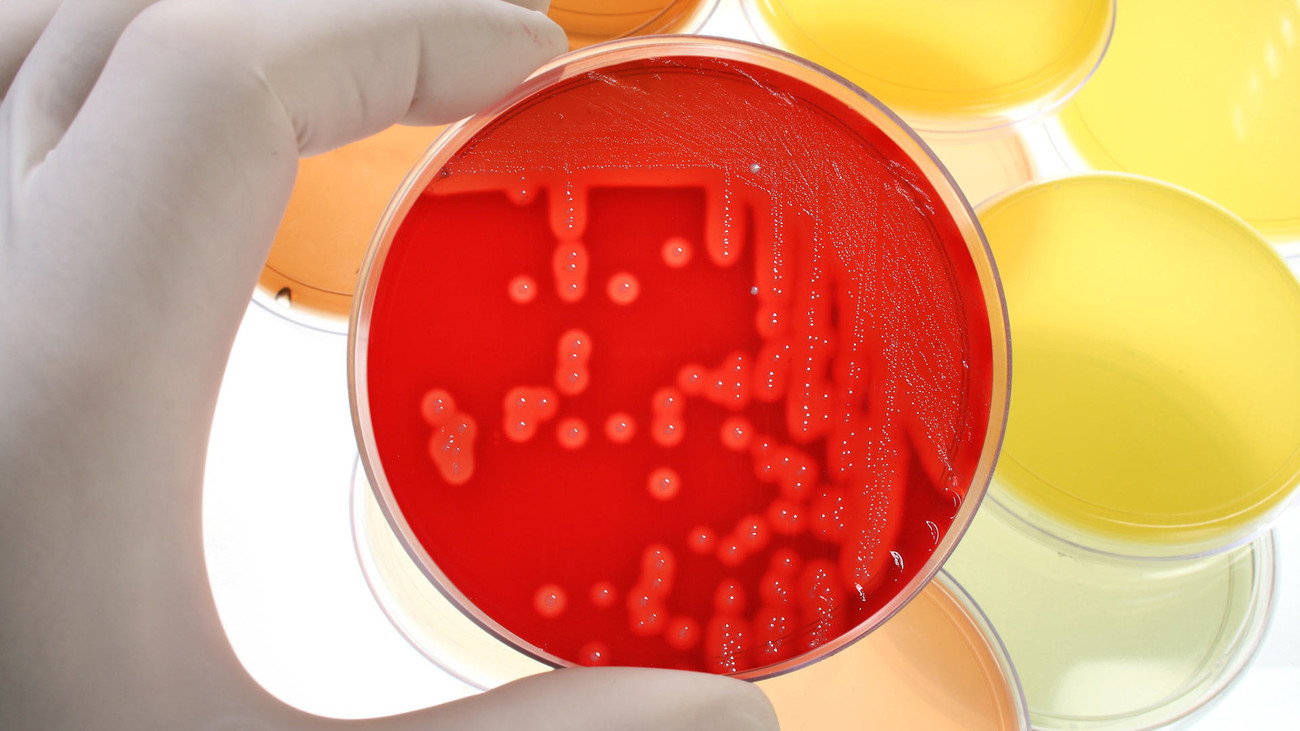

Диета » Строение тела и метаболизм » Кишечные бактерии и стройность
Кишечные бактерии и стройность
Кишечные бактерии и стройность
Диета - 2016
Знаете ли вы, что кишечные бактерии являются самыми верными нашими друзьями и союзниками, когда речь идет о сбрасывании веса и поддержании оптимальной массы тела на длительный срок? Если вы еще об этом не слышали, это не удивительно, поскольку ученые занимаются исследованиями в этой области только в течение последних двух лет, и постепенно они начинают понимать, какой силой обладают эти маленькие микробы. Эти бактерии могут эффективно заставить растаять жировые отложения, сдержать аппетит и улучшить наше настроение. Ученые солидарны во мнении, что только тот человек может в течение длительного времени оставаться стройным, чья кишечная флора функционирует правильно.
Этот факт до недавнего времени полностью игнорировался диетологами. Надо не только бороться со складками жира, но и одновременно заботиться о своих кишечных бактериях. Тогда Вы будете иметь хорошие шансы на длительное время сохранить стройность. Как же заставить работать свои кишечные бактерии и запрограммировать пищеварительную систему на похудение? Работу кишечника мы обсуждаем весьма неохотно, даже в кругу семьи или с лучшими друзьями. Говорить об этом неудобно, не только из-за "конечного продукта" нашего пищеварительного тракта. Но все-таки стоит проявить к функции кишечника хотя бы небольшой интерес, поскольку наш кишечник обладает очень интересными свойствами. Когда в прошлом шла речь о сбрасывании веса, полностью игнорировались возможности, которые в прямом смысле слова дремали в нас.
Однако с помощью диеты на основе кишечных бактерий Вы можете воспользоваться интересными особенностями кишечных микробов для своей пользы. Если Вы будете благосклонны к своей кишечной флоре, это восполнится многочисленными преимуществами – Вы наконец-то сможете сбросить надоевшие килограммы. Важно правильно питаться, употребляя полезные для здоровья продукты – кисломолочную продукцию, нежирное мясо, молоко, овощи и фрукты. Золотистые стафилококки начинают активно размножаться, если питаться неправильно, употребляя жирную и калорийную пищу, булки. Это приводит к быстрому набору веса.
БАРИАТРИЯ - самый эффективный на сегодня в мире метод ПОХУДЕНИЯ и УДЕРЖАНИЯ ВЕСА после ПОХУДЕНИЯ.
ДНЕВНИКИ бариатрических пациентов – информация из ПЕРВЫХ РУК
Расскажем ВСЕ об операциях для похудения +7-925-736-25-65
- Как ускорить обмен веществ?
- На что расходуется энергия?
- Влияние гормонов на обмен веществ
- Воздействие диеты на обмен веществ
- Еда и напитки, ускоряющие обмен веществ
- Можно ли быстро потолстеть?
- Пищевые добавки, ускоряющие обмен веществ
- Повышенный аппетит
- Программа действий для ускорения обмена веществ
- Режим питания, способствующий ускорению обмена веществ
- Формула энергетического баланса
- Расчет скорости обмена веществ
- «Груша» и «Яблоко» – два типа отложения жира
- Андроидная фигура. Основные проблемы снижения веса
- Возрастные изменения фигуры
- Гиноидная фигура. Основные проблемы снижения веса
- Изменение веса с возрастом
- Изменение процента содержания жира при соблюдении диет
- Индекс массы тела
- Недостаточный вес
- Ожирение и гены
- Определение идеального веса
- Плоский живот. Фантазия или реальность?
- Правильная осанка – самый быстрый способ стать стройнее
- Привлекательная попка и красивая грудь
- Процент содержания жира
- Скелет и костная ткань
- Структура тела. Сколько весит жир
- Три основных типа фигуры
- Факторы, формирующие индивидуальные особенности фигуры
- Процесс пищеварения
- Антицеллюлитная диета
- Пролактин и ожирение
- Кортизол и ожирение
- Нарушение углеводного обмена
- Сахарный диабет, как следствие ожирения
- Патология обмена веществ, как причина ожирения
- Как нужно изменить образ жизни, чтобы похудеть?
- Почему Вы не можете похудеть?
- Важные факты о лекарствах и весе. Противозачаточные препараты
- Лекарства и вес. Сильнодействующие препараты
- Рак матки. Осложнение ожирения
- Пропорциональность фигуры
- Ожирение по мужскому типу
- Алиментарное ожирение
- Ожирение сердца. Анатомические особенности сердца
- Болезни и лекарства, из-за которых можно набрать вес
- Метаболическая диета
- Полезные бактерии кишечника
- Бактерия Аккермансия и похудение
- Бифидобактерии
- Фирмикуты
- Балластные вещества в кишечнике
- Бактерии молочной кислоты
- Как определить состояние микрофлоры в кишечнике?
- Что такое пропускающий кишечный барьер?
- Существует ли микроб мужества? Молочнокислые бактерии
- Как поддержать кишечную микрофлору в оптимальном состоянии?
- Жизненное пространство кишечных бактерий
- Кишечные бактерии и стройность
- Микробиом у стройных и полных людей
- Влияние кишечных бактерий на здоровье
- Кишечные бактерии, как сбалансированная экосистема
- Кишечные микробы
- Переваривание пищи и кишечные микробы
- Не все бактерии плохие
- Кишечный дисбактериоз
- Барьерная функция кишечника
- Маркер воспаления и лишний вес
- Кишечные бактерии и эмоции
- Как связаны нервная система и кишечник
- Как общаются кишечник и голова?
- Сахар, энергия и лишний вес
- Кишечная бактерия, вызывающая токсоплазмоз
- Синдром раздраженного кишечника
- Подсознание и работа кишечника
- Нарушение работы кишечника и синдром гиперактивности
- Как диагностируется синдром дефицита внимания и гиперактивности? Как СДВГ связано с нарушением работы кишечника?
- Насыщенные и ненасыщенные жиры
- Инсулин, кортизол и кишечные бактерии
- Бактерии и иммунитет
- Фирмикуты
- Почему мы быстрее поправляемся зимой?
- Диагностика гестационного диабета
- Диабет - первый и второй тип